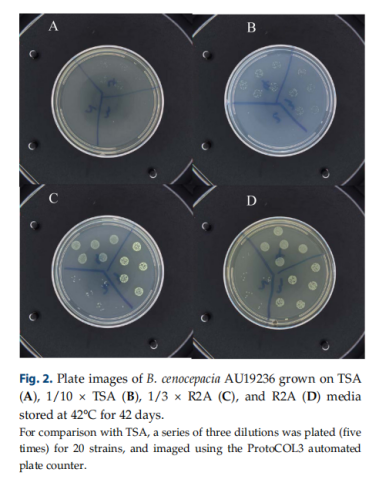
image.png

寡營養(yǎng)培養(yǎng)基與胰酪大豆胨瓊脂或肉湯在不同儲存溫度和培養(yǎng)條件下回收洋蔥伯克霍爾德氏菌的比較
2024-05-18 15:05:17
洋蔥伯克霍爾德氏菌復合體(BCC)能夠在低營養(yǎng)環(huán)境和惡劣條件下保持存活,對非無菌藥品構成污染風險,且難以檢測。BCC分離株是污染無菌和非無菌藥品的一些最常見的微生物,最近爆發(fā)的幾次感染與被發(fā)現(xiàn)的含有BCC的防腐劑有關。含水產(chǎn)品尤其危險,因為BCC能夠在惡劣條件下保持活力,包括防腐劑的存在。本研究的目的是評估使用寡營養(yǎng)培養(yǎng)基的BCC,與使用TSA或TSB在不同的無菌蒸餾水樣品中保存溫度以及不同的防腐劑濃度下的恢復情況,并進行比較。因此推薦這篇文章給大家,希望能對大家有所幫助。
Oligotrophic Media Compared with a Tryptic Soy Agar or Broth for the Recovery of Burkholderia cepacia Complex from Different Storage Temperatures and Culture Conditions

內(nèi)容
摘要:洋蔥伯克霍爾德氏菌菌群(BCC)能夠在低營養(yǎng)環(huán)境和惡劣條件下保持存活,對非無菌藥品構成污染風險,并對檢測構成挑戰(zhàn)。為了建立檢測BCC的最佳回收方法,我們對三種寡營養(yǎng)培養(yǎng)基進行了評價,并用營養(yǎng)培養(yǎng)基從高壓蒸餾水或防腐溶液中回收BCC進行了比較。將20株BCC菌株連續(xù)稀釋后(10-1~10-12 CFU/ml)接種到高壓蒸餾水中,在6℃、23℃和42℃條件下保存42天。用6種洋蔥伯克霍爾德氏菌懸液接種含5 μg/ml和50 μg/ml氯己定葡萄糖酸酯(CHX)和10 μg/ml苯扎氯銨(BZK)的水溶液,并在23℃再儲存199天。營養(yǎng)培養(yǎng)基,如胰蛋白酶大豆瓊脂(TSA)或胰蛋白酶大豆肉湯(TSB),少營養(yǎng)培養(yǎng)基(1/10強度的TSA或TSB,R2A或R2AB,和1/3強度R2A或R2AB,使用這些培養(yǎng)基接種從高壓蒸餾水和防腐樣品的BCC。液體培養(yǎng)基中BCC(水中或防腐劑中)的回收率高于固體培養(yǎng)基。寡營養(yǎng)培養(yǎng)基對20株BCC樣品的回收效率高于TSA或TSB。多重比較的結果使我們能夠直接識別TSA或TSB與寡營養(yǎng)培養(yǎng)基之間的顯著差異。美國藥典(USP)提出的BCC檢測的簡單檢測方法提供了一種寡營養(yǎng)培養(yǎng)基預富集復蘇步驟。
材料和方法:
寡培養(yǎng)基的制備:

結果:
不同儲存溫度下TSB和R2AB的生長動力學:為了了解溫度對存活的影響,將20株BCC在3種溫度(6℃、23℃和42℃)下保存42天,并在不同的培養(yǎng)基中恢復。綜合結果,在6℃、23℃和42℃下觀察到存活,沒有發(fā)現(xiàn)物種特異性的趨勢。當培養(yǎng)基接種初始濃度為102-100 CFU/ml(在蒸餾水6℃和23℃保存42天),108-106 CFU/ml(在蒸餾水42°C保存42天時),觀察到洋蔥AU19236的生長。在TSB、1/10×TSB、R2AB和1/3×R2AB中觀察了AU19236在30℃培養(yǎng)24 h后的生長,并使用Baranyi模型描述了動力學。接種TSB、1/10×TSB、R2AB和1/3×R2AB的AU19236擬合的生長曲線平均r2值為> 0.98。由于回歸線與觀測數(shù)據(jù)點近似,因此在平均生長曲線中得到了較高的r2值。在6℃保存的蒸餾水中培養(yǎng),顯示出更長的滯后時間(λ),范圍在17.6-27.4h之間(圖1A)。在23℃和42℃(分別為10.1和14.2h)下估計的滯后時間沒有顯著差異(1B和1C)。在6℃和23℃時,1/10×TSB、R2AB和1/3×R2AB的滯后時間值(λ)大于TSB,但在42℃時,滯后時間值不大。此外,無論使用何種培養(yǎng)基生長速度(μ)沒有顯著差異(p > 0.05),盡管寡營養(yǎng)的生長培養(yǎng)基(如1/10×TSB,R2AB和1/3×R2AB在23℃和42℃)增長率更大。

不同儲存溫度下TSA與寡營養(yǎng)固體培養(yǎng)基比較:為了評估固體培養(yǎng)基中的活菌落計數(shù),使用ProtoCOL3自動平板計數(shù)器對每個平板進行計數(shù)。
經(jīng)過42天的培養(yǎng),在6°C(104-108 CFU/ml)和23°C(107-1012 CFU/ml)的濃度下,所有的瓊脂都很容易恢復。然而,在42°C(102-106 CFU/ml)的蒸餾水中當20株BCC菌株被接種在固體培養(yǎng)基上時,只有8株BCC菌株42天后生長。其余菌株培養(yǎng)9天后沒有在固體培養(yǎng)基上生長。
在6°C儲存42天后,所有瓊脂的回收率約為104 -108 CFU/ml。B. lata HI4002,B. cenocepacia HI2976 和 B. cenocepacia HI2485 為BCC菌株,菌落計數(shù)較高,達到108 CFU/ml。1/3×R2A(1.79 ± 6.81×108 CFU/ml)和R2A(1.95 ± 7.31×108 CFU/ml)的菌落計數(shù)略高于TSA(1.67 ± 6.41×108 CFU/ml)的菌落計數(shù)。采用Mann-Whitney Rank Sum Test比較TSA與1/10×TSA、1/3×R2A和R2A之間的差異,差異無統(tǒng)計學意義(p < 0.05)。在23°C的蒸餾水中,在各種培養(yǎng)基上,1012 CFU/ml BCC的初始濃度保持不變。1/10×TSA(4.18 ± 6.17×1012 CFU/ml)、1/13×R2A(4.17 ± 5.62×1012 CFU/ml)和R2A(4.46 ± 5.78×1012 CFU/ml)的菌落計數(shù)均高于TSA(3.44 ± 5.09×1012 CFU/ml)。采用Mann-Whitney Rank Sum Test比較TSA與R2A的差異,發(fā)現(xiàn)差異有統(tǒng)計學意義(p < 0.041)。

在42°C時,只有8株菌株生長到約105 CFU/ml。1/10×TSA(2.01 ± 4.17×105 CFU/ml)、1/3×R2A(6.56 ± 15.05×105 CFU/ml)和R2A(6.53 ± 14.72×105 CFU/ml)的菌落數(shù)量比TSA(0.57±1.39±1.39×105 CFU/ml)更高。采用Mann-Whitney Rank Sum Test比較TSA與寡營養(yǎng)培養(yǎng)基的差異,如1/10×TSA(p = 0.008)、1/3×R2A(p < 0.001)和R2A(p < 0.001)。
不同儲存溫度下TSB和寡營養(yǎng)肉湯培養(yǎng)基的比較:對TSB、1/10×TSB、1/3×R2AB和R2AB肉湯培養(yǎng)基在6°C、23°C和42°C下恢復BCC的能力進行了評估。

在6°C存儲時,與1/10×TSB、1/3×R2AB和R2AB相比,TSB介質(zhì)中的回收效率較低,回收率分別為351/480(回收次數(shù)/測試次數(shù))、345/480和353/480。對接種的菌落數(shù)最低(10-12)的4個肉湯的評價表明,1/10×TSB、1/3×R2AB和R2AB支持從23°C存儲中回收BCC。在480次試驗中,分別有39、94、94、107、79個TSB、1/10×TSB、1/3×R2AB和R2AB培養(yǎng)基中BCC的回收率存在差異。統(tǒng)計分析顯示,TSB的有效性低于1/10×TSB。
CHX和BZK的恢復
TSA和稀釋固體培養(yǎng)基在不同濃度的防腐劑下的比較:將6株菌株懸浮在5和50 μg/ml CHX或10 μg/ml BZK中。在5和50 μg/ml的CHX溶液中,1/10×TSA(7.06 ± 6.5×104 CFU/ml,3.73 ± 3.93×103 CFU/ml)的菌落計數(shù)略高于TSA(6.59 ± 5.12×104 CFU/ml,3.03 ± 3.42×103 CFU/ml),分別如下圖:

采用Mann-Whitney Rank Sum Test比較TSA與1/10×TSA的差異,兩組間差異無統(tǒng)計學意義(p < 0.05)。此外,在10 μg/mlBZK溶液中,1/10×TSA(1.51 ± 1.77×103 CFU/ml)、1/3×R2A(1.58 ± 1.73×103 CFU/ml)、R2A(129±2.24×103 CFU/ml)的菌株數(shù)量分別略高于TSA(1.27 ± 1.28×103 CFU/ml)。
不同濃度防腐劑下TSB和少營養(yǎng)肉湯培養(yǎng)基的比較:對TSB、1/10×TSB、1/3×R2AB和R2AB肉湯培養(yǎng)基在5和50 μg/ml CHX或10 μg/ml BZK中恢復BCC的能力進行評價。在R2AB介質(zhì)中恢復效率更高,恢復數(shù)量分別為134/144(恢復次數(shù)/試驗次數(shù),從5 μg/ml of CHX)、114/144(50 μg/ml of CHX)和113/144(10 μg/ml of BZK)。

數(shù)據(jù)統(tǒng)計分析顯示,TSB和R2AB的CHX的5μg/ml(χ2統(tǒng)計= 6.9231,p = 0.0085)、50 μg/ml的CHX(χ2統(tǒng)計= 9.8223,p = 0.0017)和10 μg/ml的BZK(χ2統(tǒng)計= 31.3481,p < 0.05)之間存在顯著差異。
討論:
洋蔥伯克霍爾德氏菌復合體(BCC)能夠在低營養(yǎng)環(huán)境和惡劣條件下保持存活,對非無菌藥品構成污染風險,并對檢測構成挑戰(zhàn)。為了建立檢測BCC的最佳回收方法,作者對三種寡營養(yǎng)培養(yǎng)基進行了評價,并與營養(yǎng)培養(yǎng)基從高壓蒸餾水或防腐溶液中回收BCC進行了比較。將20株BCC菌株連續(xù)稀釋后(10-1~10-12 CFU/ml)接種到高壓蒸餾水中,在6℃、23℃和42℃條件下保存42天。用6種洋蔥伯克霍爾德氏菌懸液接種含5 μg/ml和50 μg/ml氯己定葡萄糖酸酯(CHX)和10 μg/ml苯扎氯銨(BZK)的水溶液,并在23℃再儲存199天。營養(yǎng)培養(yǎng)基,如胰蛋白酶大豆瓊脂(TSA)或胰蛋白酶大豆肉湯(TSB),少營養(yǎng)培養(yǎng)基(1/10強度的TSA或TSB,R2A或R2AB,和1/3強度R2A或R2AB)通過接種高壓蒸餾水和防腐樣品的BCC到培養(yǎng)基中。肉湯培養(yǎng)基中水中或防腐劑中BCC的回收率高于固體培養(yǎng)基。寡營養(yǎng)培養(yǎng)基對20BCC樣品的回收效率高于TSA或TSB。多重比較的結果使我們能夠直接識別TSA或TSB與寡營養(yǎng)培養(yǎng)基之間的顯著差異。


0513-85596088





